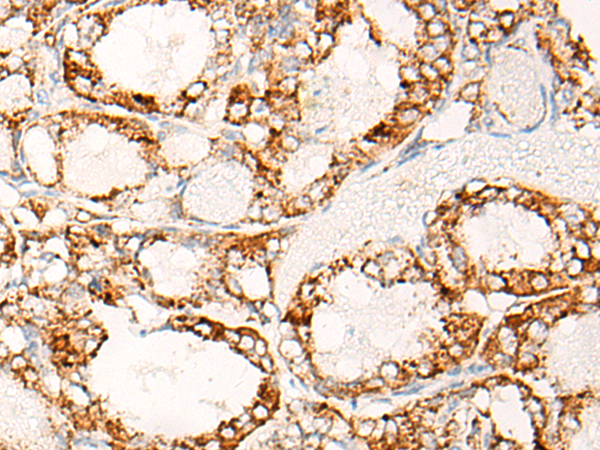
一抗

中文名稱: 兔抗ABCC5多克隆抗體
英文名稱: Anti-ABCC5 rabbit polyclonal antibody
別 名: MRP5, SMRP, ABC33, MOATC, MOAT-C, pABC11, EST277145
相關(guān)類別: 一抗
儲 存: 冷凍(-20℃)
宿 主: Rabbit
抗 原: ABCC5
反應(yīng)種屬: Human, Mouse, Rat
標(biāo) 記 物: Unconjugate
克隆類型: rabbit polyclonal
技術(shù)規(guī)格
|
Background: |
The protein encoded by this gene is a member of the superfamily of ATP-binding cassette (ABC) transporters. ABC proteins transport various molecules across extra- and intra-cellular membranes. ABC genes are divided into seven distinct subfamilies (ABC1, MDR/TAP, MRP, ALD, OABP, GCN20, White). This protein is a member of the MRP subfamily which is involved in multi-drug resistance. This protein functions in the cellular export of its substrate, cyclic nucleotides. This export contributes to the degradation of phosphodiesterases and possibly an elimination pathway for cyclic nucleotides. Studies show that this protein provides resistance to thiopurine anticancer drugs, 6-mercatopurine and thioguanine, and the anti-HIV drug 9-(2-phosphonylmethoxyethyl)adenine. This protein may be involved in resistance to thiopurines in acute lymphoblastic leukemia and antiretroviral nucleoside analogs in HIV-infected patients. Alternative splicing of this gene has been detected; however, the complete sequence and translation initiation site is unclear. |
|
Applications: |
ELISA, WB, IHC |
|
Name of antibody: |
ABCC5 |
|
Immunogen: |
Synthetic peptide of human ABCC5 |
|
Full name: |
ATP-binding cassette, sub-family C |
|
Synonyms: |
MRP5, SMRP, ABC33, MOATC, MOAT-C, pABC11, EST277145 |
|
SwissProt: |
O15440 |
|
ELISA Recommended dilution: |
2000-10000 |
|
IHC positive control: |
Human ovarian cancer and Human lung cancer |
|
IHC Recommend dilution: |
50-200 |
|
WB Predicted band size: |
161 kDa |
|
WB Positive control: |
Mouse heart tissue |
|
WB Recommended dilution: |
1000-5000 |


 購物車
購物車 幫助
幫助
 021-54845833/15800441009
021-54845833/15800441009